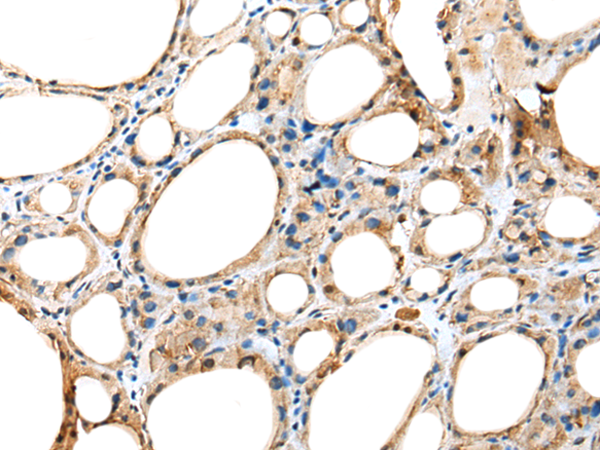
一抗

|
Background: |
The protein encoded by this gene is essential for the preassembly or stability of axonemal dynein arms, and is found only in organisms with motile cilia and flagella. Mutations in this gene are associated with primary ciliary dyskinesia-18, a disorder characterized by abnormalities of motile cilia. Alternatively spliced transcript variants have been found for this gene. |
|
Applications: |
ELISA, IHC |
|
Name of antibody: |
DNAAF5 |
|
Immunogen: |
Fusion protein of human DNAAF5 |
|
Full name: |
dynein, axonemal, assembly factor 5 |
|
Synonyms: |
CILD18; HEATR2 |
|
SwissProt: |
Q86Y56 |
|
ELISA Recommended dilution: |
5000-10000 |
|
IHC positive control: |
Human thyroid cancer |
|
IHC Recommend dilution: |
25-100 |

 購(gòu)物車
購(gòu)物車 幫助
幫助
 021-54845833/15800441009
021-54845833/15800441009